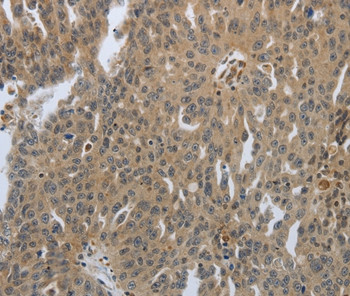
PTPRT Antibody in Immunohistochemistry (Paraffin) (IHC (P))

Search
Invitrogen
PTPRT Polyclonal Antibody
{{$productOrderCtrl.translations['antibody.pdp.commerceCard.promotion.promotions']}}
{{$productOrderCtrl.translations['antibody.pdp.commerceCard.promotion.viewpromo']}}
{{$productOrderCtrl.translations['antibody.pdp.commerceCard.promotion.promocode']}}: {{promo.promoCode}} {{promo.promoTitle}} {{promo.promoDescription}}. {{$productOrderCtrl.translations['antibody.pdp.commerceCard.promotion.learnmore']}}

Please note: We are reviewing Western blot images included in the antibody testing data in our catalog, including those provided by third parties. Unless expressly labeled or annotated as “raw-unedited”, Western blot images included in the antibody testing data in our catalog may have been edited, optimized or otherwise adjusted for presentation.
产品信息
PA5-50568
种属反应
宿主/亚型
分类
类型
抗原
偶联物
形式
浓度
规格
纯化类型
保存液
内含物
保存条件
运输条件
RRID
产品详细信息
The antibody detects endogenous levels of total PTPRT protein.
靶标信息
The protein encoded by this gene is a member of the protein tyrosine phosphatase family. PTPs are known to be signaling molecules that regulate a variety of cellular processes including cell growth, differentiation, mitotic cycle, and oncogenic transformation. This PTP possesses an extracellular region, a single transmembrane region, and two tandem intracellular catalytic domains, and thus represents a receptor-type PTP. The extracellular region contains a meprin-A5 antigen-PTP domain, Ig-like and fibronectin type III-like repeats. The protein domain structure and the expression pattern of the mouse counterpart of this PTP suggest its roles in both signal transduction and cellular adhesion in the central nervous system. Two alternatively spliced transcript variants of this gene, which encode distinct proteins, have been reported.
仅用于科研。不用于诊断过程。未经明确授权不得转售。
篇参考文献 (0)
生物信息学
蛋白别名: R-PTP-T; receptor protein tyrosine phosphatase-rho; Receptor-type tyrosine-protein phosphatase rho; Receptor-type tyrosine-protein phosphatase T; RP5-1121H13.2; RPTP-rho; RPTPmam4
基因别名: KIAA0283; mKIAA0283; mRPTPrho; PTPRT; R-PTP-T; RPTP-rfo; RPTP-rho; RPTPmam4; RPTPrho
UniProt ID: (Mouse) Q99M80
Entrez Gene ID: (Mouse) 19281